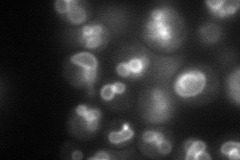
YCL038C
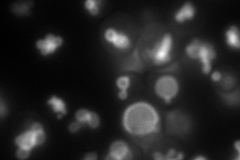
YCL038C
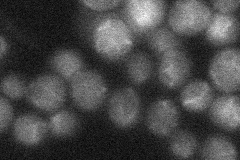
YCL038C
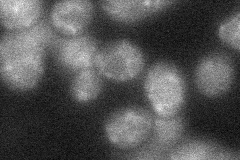
YCL038C

View description
Vacuolar integral membrane protein required for efflux of amino acids during autophagic body breakdown in the vacuole; null mutation causes a gradual loss of viability during starvation
Localization:
Intensity:
Fold change:
Significance:
-
C’ GFP library in SD

below threshold15.76 -
N' NOP1pr-GFP in SD
vacuole membrane92.2029 -
N' TEF2pr-mCherry in SD
vacuole membrane158.469 -
N' NATIVEpr-GFP in SD
below threshold23.4044 -
N' TEF2pr-VC and Cyto-VN in SD
below threshold29.6647 -
C’ GFP library in SD+DTT

cytosol16.371.03No -
C’ GFP library in SD+H2O2

cytosol15.470.98No -
C’ GFP library in Starvation Media

cytosol19.481.23No -
C’ GFP library on the background of Pup2-DaMP

below threshold -
C’ GFP library on the background of CCT mutant

below threshold13.54650.858873No
